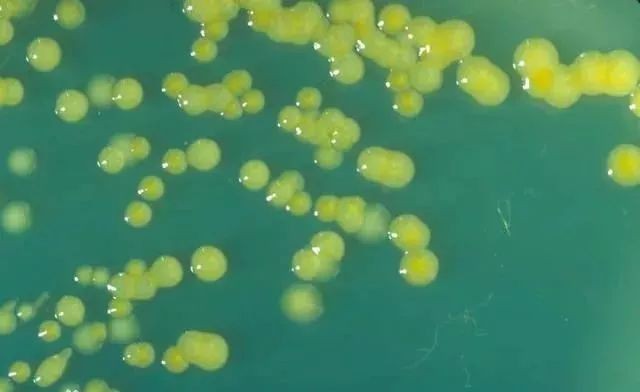
什么奶粉不受核污染影响,多国奶粉受污染怎么办

本文专家:刘少伟,华东理工大学食品药品监管研究中心副主任、教授,美国宾夕法尼亚州立大学食品科学博士,美国堪萨斯州立大学博士后
每位孩子都是爸妈手心的宝,而宝宝的口粮是爸爸妈妈们最关心的问题。相比之下,很多妈妈喜欢给孩子买进口奶粉,然而国外的奶粉也会出事故。

近日,国家质检总局网站发布公告称:近日,欧盟食品饲料快速预警系统通报,一批由荷兰企业生产的婴幼儿配方奶粉疑似遭到致病菌阪崎肠杆菌的污染。相关产品已出口到中国、越南、沙特阿拉伯等国家。

根据国家质检总局的官方信息显示,现已查明,欧盟通报所涉及产品中,对华出口的为Lypack (注册号NL Z0238 EC) 生产的润贝婴儿配方乳粉 (Rearing Baby),生产批号为0000011087和0000011079。该货物目前在口岸监管仓库,尚未进入流通领域,检验检疫机构将会对该批货物依法处理;疑似受污染的其他批次产品没有对华出口,境内消费者可以放心。

在此,提醒各位宝爸宝妈,如果是海外代购,可一定要看清楚生产批次哦。那么,阪崎肠杆菌到底是什么?有什么危害呢?今天就和大家来详细的聊一聊!
阪崎肠杆菌到底是什么?
阪崎肠杆菌是肠杆菌科的一种,它是人和动物肠道内寄生的一种革兰阴性无芽孢杆菌。1980年由黄色阴沟肠杆菌更名为阪崎肠杆菌。阪崎肠杆菌自然来源非常广泛,在水、土壤、植物根茎、动物肠道甚至加工食品都可存在,其中婴儿配方奶粉是婴儿感染阪崎肠杆菌的主要渠道。
阪崎肠杆菌的生命力非常顽强,它耐寒、耐热、耐干燥、耐酸碱、耐渗透压、耐紫外线,对消毒杀菌剂也有比较强的抵抗力。它在遇到不利条件的时候,会迅速分泌多糖成分将自己包裹起来,这些多糖不仅可以保护它还具有粘附性,所以一旦污染食品生产线,十分难以去除。
阪崎肠杆菌可以在非常干燥的环境里(比如婴儿配方粉)存活2年之久,且能承受58-68度的温度。

阪崎肠杆菌是肠道正常菌丛中的一种,在一定条件下可引起人和动物致病,所以称为“条件致病菌”。它主要攻击目标是婴幼儿和老人,但最常见于新生儿、早产儿、出生体重低下或免疫力低下的婴儿。较大的婴儿和成年人有肠道菌群的保护,通常不容易受到阪崎肠杆菌的袭击。
阪崎肠杆菌的危害有多大?
阪崎肠杆菌能引起严重的新生儿脑膜炎、小肠结肠炎和菌血症。在某些情况下,由阪崎肠杆菌引发疾病而导致的死亡率可达40%-80%。
不过,它也没有那么可怕,阪崎肠杆菌感染并非是不治之症,用抗生素就可以有效控制。根据美国的数据,1岁以下婴儿的感染率只有十万分之一,低体重新生儿感染率为十万分之8.7。

虽然阪崎肠杆菌的毒力因子和致病性现在还不太清楚,但已发现有些阪崎肠杆菌可能产生一种毒力因子——类肠毒素样化合物。而且,经过组织培养也发现一些菌株可产生细胞毒效应。
如何防范来降低风险?
1. 注意卫生,喂奶器定期消毒
对于一般的婴儿,阪崎肠杆菌和其他致病菌相比并没有特别的威胁,只需要注意保持家庭环境的清洁卫生即可。冲调婴儿奶粉要保持良好的卫生习惯,冲调前认真洗手,奶瓶等喂养工具彻底清洁和消毒。
2. 选择无菌液态奶
对于半岁以下的婴儿,尤其是高危婴儿,包括早产儿、低体重儿或其他免疫功能低下的婴儿,有条件的情况下尽量选择无菌的液体配方奶。

3. 正确冲调奶粉
根据世界卫生组织和联合国粮农组织(WHO/FAO)2007年联合发布的《安全制备、贮存和操作婴儿配方奶粉指导原则》,使用不低于70℃水调配婴儿配方奶粉可显著降低危险。
4. 正确控制储存温度
奶是很好的细菌培养基,因此没喝完的或不想马上喂给孩子的奶需要贮存在5℃以下,防止细菌繁殖,再喝之前还要充分加热。

5. 首选母乳喂养
从营养角度来看,母乳喂养的好处已无需赘述,也逐渐被越来越多人认可。从安全角度来看,母乳喂养依然是最好的选择,可以使婴儿远离可能存在于配方奶粉中的风险。
科普百分百·助力科普中国,让科学知识在网上和生活中流行起来。温馨提示:以上为科普百分百网上阅读所浏览内容,转载分享只为知识传播和学习宣传,本文内容仅代表原作者观点,如有意见建议,请私信留言,我们会及时处理。欢迎关注,谢谢。